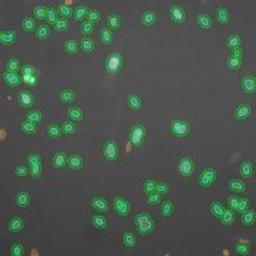
Molecular Translocation V2 Image Analysis BioApplication for Kinase and transcription factor activation - null - Lab Informatics
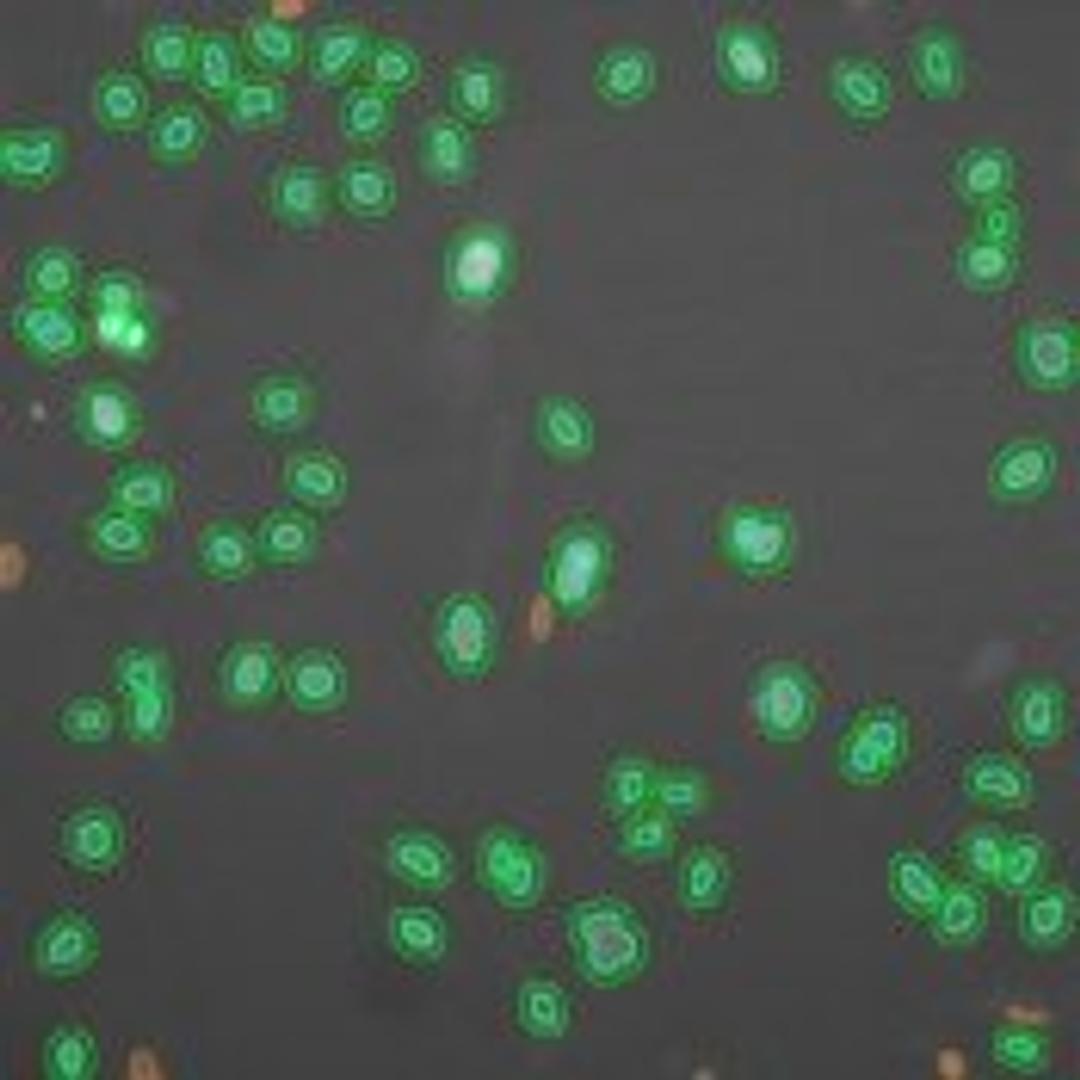
Molecular Translocation V2 Image Analysis BioApplication for Kinase and transcription factor activation - null - Lab Informatics

Molecular Translocation V2 Image Analysis BioApplication for Kinase and transcription factor activation
Molecular Translocation V2 is an advanced image analysis application for quantitating simultaneous cytoplasm-to-nucleus translocation of multiple targets. It features subpopulation selection and cross-correlated responder analysis of up to 5 distinct targets, allowing study of signaling pathways. This application has been biologically validated, enhancing confidence in your image-based data. Available for the Cellomics Ar…
Molecular Translocation V2 is an advanced image analysis application for quantitating simultaneous cytoplasm-to-nucleus translocation of multiple targets. It features subpopulation selection and cross-correlated responder analysis of up to 5 distinct targets, allowing study of signaling pathways.
This application has been biologically validated, enhancing confidence in your image-based data. Available for the Cellomics ArrayScan VTI, ArrayScan x.5, and KineticScan platforms.